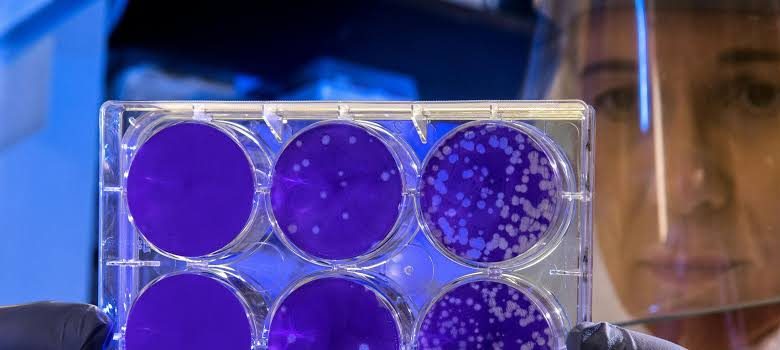

منوعات
علماء روس يبتكرون مادة مضافة للبلاستيك تقاوم الحرائق
وكالات
توصل علماء روس من جامعة فولغوغراد التقنية إلى ابتكار مادة مضافة للبلاستك تقلل من قابليته للاشتعال، وتمنح المواد المعالجة بها قدرة على مقاومة انتشار اللهب تفوق المواد التقليدية بخمسة أضعاف.
وتتكون المادة المضافة الجديدة من محلول يضم أملاح النحاس والأمونيوم وحمض الفوسفوريك تمتزج بالبوليمر عند دمجها معه لتشكل بنية جديدة تعمل في ثلاثة اتجاهات متزامنة ، بحيث ينشئ الفوسفور طبقة واقية على السطح تشبه طبقة فحم الكوك، ويطلق النيتروجين غازات غير قابلة للاشتعال تقلل من شدة اللهب، ويحفز النحاس التفاعلات الكيميائية التي تثبط عملية الاحتراق.
ولتحقيق هذا التأثير، لا تحتاج المادة المضافة إلى أكثر من نحو 8% من وزن المادة الإجمالي، مع بقاء قوة البلاستيك شبه ثابتة، كما يعزز هذا التركيب ميوعة المواد الخام أثناء عمليات الإنتاج.
وذكر سيرغي بوريسوف، الأستاذ المشارك في قسم كيمياء وتكنولوجيا معالجة المطاط في الجامعة، أن مركبات البوليمر المقواة تستخدم على نطاق واسع في قطاعات البناء والطيران والإلكترونيات وصناعة السيارات.






